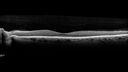

|

Pseudophakic cystoid macular edema (CME)158 views66 year old female 4 months following cataract surgery. Never had very good vision after surgery. On PF QID for one month. VA 20/50 in both eyes.
|
|

Pseudophakic cystoid macular edema (CME)158 views66 year old female 4 months following cataract surgery. Never had very good vision after surgery. On PF QID for one month. VA 20/50 in both eyes.
|
|

Pseudophakic cystoid macular edema (CME)158 views66 year old female 4 months following cataract surgery. Never had very good vision after surgery. On PF QID for one month. VA 20/50 in both eyes.
|
|

Pseudophakic cystoid macular edema (CME)158 views66 year old female 4 months following cataract surgery. Never had very good vision after surgery. On PF QID for one month. VA 20/50 in both eyes.
|
|

Radiation Retinopathy Both Eyes - 2023 - Two years after radiation for ocular lymphoma (7)158 views
|
|

Dome Shaped Macula Left Eye158 views73 year old female Diagnosed with POHS in the past and treated with laser in the right eye in 1994 with vision loss. She moved from Tampa to Largo in 2017 and started seeing Dr. Cohen. She had her last injection in the left eye 2015 prior to moving to Largo. She has been treated intermittently in the left eye and has been resistant to Anti-VEGF injections. Her vision is good in the left eye. Images are from April 2023 one month following a Vabysmo injection in the left eye.
PMHx- thyroid disease
Meds: Synthroid
VA 20/200 OD, 20/25 OS
|
|

Dome Shaped Macula Left Eye158 views73 year old female Diagnosed with POHS in the past and treated with laser in the right eye in 1994 with vision loss. She moved from Tampa to Largo in 2017 and started seeing Dr. Cohen. She had her last injection in the left eye 2015 prior to moving to Largo. She has been treated intermittently in the left eye and has been resistant to Anti-VEGF injections. Her vision is good in the left eye. Images are from April 2023 one month following a Vabysmo injection in the left eye.
PMHx- thyroid disease
Meds: Synthroid
VA 20/200 OD, 20/25 OS
|
|

157 views
|
|

wet AMD - extrafoveal classic choroidal neovascular membrane157 views72 year old man with good vision in both eyes. Extrafoveal classic cnvm was picked up and treated with vabysmo
|
|

Stargardt Disease - Very Mild - 24 year old157 viewsThis patient has 3 different ABCA4 mutations. His mother and sister have stargardts and his father has RP. His sisters images are also on Retinagallery.com
|
|

Central Serous Chorioretinopathy - Expanding hot spot - photodynamic laser157 views35 year old man with acute central serous chorioretinopathy. The fluid got better then worse and the patient was treated with full strength juxtafoveal PDT and then got better.
|
|

Central Serous Chorioretinopathy - Expanding hot spot - photodynamic laser157 views35 year old man with acute central serous chorioretinopathy. The fluid got better then worse and the patient was treated with full strength juxtafoveal PDT and then got better.
|
|

Central Serous Chorioretinopathy - Expanding hot spot - photodynamic laser157 views35 year old man with acute central serous chorioretinopathy. The fluid got better then worse and the patient was treated with full strength juxtafoveal PDT and then got better.
|
|

Central Serous Chorioretinopathy - Expanding hot spot - photodynamic laser157 views35 year old man with acute central serous chorioretinopathy. The fluid got better then worse and the patient was treated with full strength juxtafoveal PDT and then got better.
|
|

Macular telangiectasia - images from 10 years later - crystals 157 views75 year old man with MacTel and a lot of crystals VA 20/63 OD, 20/50 OS.
|
|

Macular telangiectasia - images from 10 years later - crystals 157 views75 year old man with MacTel and a lot of crystals VA 20/63 OD, 20/50 OS.
|
|

Large chronic choroidal nevus157 viewsAutofluorescence image shows guttering at the bottom of the lesion suggesting chronicity. This was documented 23 years prior to these photos
|
|

Twig (Macular) Branch Retinal Vein Occlusion with no symptoms157 views73 year old female with 20/25 vision and no symptoms
|
|
Twig (Macular) Branch Retinal Vein Occlusion with no symptoms157 views73 year old female with 20/25 vision and no symptoms
|
|

Radiation Retinopathy Both Eyes - 2023 - Two years after radiation for ocular lymphoma (14)157 views
|
|

Radiation Retinopathy Both Eyes - 2023 - Two years after radiation for ocular lymphoma (1)157 views
|
|

156 views
|
|

156 views
|
|

Optic nerve (disc) drusen and choroidal neovascular membrane156 views85 year old man - The left eye has had poor vision for 7-8 years. The right eye is OK. He was in for a checkup and his ophthalmologist noticed a problem and asked him to see retina doctor. Â
Medical Hx: Cancer.
Surgical Hx: Back Surgery. Gallbladder. Appendectomy. Colon Cancer.
Systemic Meds: Propafenone Hydrochloride, 225 mg oral tablet. Rosuvastatin. PAROXETINE HCL. GABAPENTIN. DONEPEZIL. Asp
VA OD: Dcc20/25-2 OS: DccCF 1ft
IOP: TP: OD:13 OS:12
Patient's right eye was treated with Avastin and was dry with one shot.
|
|

Macular Serpiginous Chorioretinopathy156 views75 year old vision with central placoid lesions. She tested negative for TB and Syphilis. The final visual acuity in both eyes was 1/200.
|
|

Macular pucker in the left eye156 viewsVision was 20/125 pre-op and 20/25 post-op.
|
|

Stargardt Disease - Very Mild - 24 year old156 viewsThis patient has 3 different ABCA4 mutations. His mother and sister have stargardts and his father has RP. His sisters images are also on Retinagallery.com
|
|

25 year old with Stargard and 2 ABCA4 mutations.156 viewsShe has worn glasses since she was a kid. Since she became an adult her vision started to deteriorate more rapidly. This seems to have been happening since she entered the accounting department for the last two years. Her vision is worse in the light especially when she is driving. She can see green lights in the night but not in the day. She sees better on a dark background than on a light background. Her mom is genetically visually impaired with Stargardts. Her father has RP. The mother was genetically tested in Boston about 23 years ago. That was when the gene was first being isolated. (The mother has seven brothers and sisters and four have stargardts and they are legally blind. Also one cousin has it.)
VA OD: Dcc20/160-1 PH20/80 Ncc20/200-2
VA OS: Dcc20/160-2 PH20/80-1 Ncc20/200-1
IOP: TP: OD:20 OS:21
|
|

Ocular Ischemia from 100 percent right carotid occlusion156 views77 year old female the vision in the right eye got much worse. She has recently been getting more severe headaches. Her vision is now blank. She went to her old GP in Wisconsin who said it might be sinus pressure. Her chiropractor did an adjustment and the chiropractor checked the patient eyes and told her to go to the eye doctor. She has been feeling pressure around her eye since the air flight.
Specialty Meds (Initial): systane prn OU. Plavix, Combivent, ASA 325, Vitamin E, Zinc.
PSH – Carotid surgery in 2000 (20 years ago), Stent 11/2022, Mastectomy 2000.
VA OD: DccCF 3ft (eccentric) NccUnable
VA OS: Dcc20/25 NccJ1
IOP: TP: OD:18 OS:16
Psuedophakic OU
Right eye had rubeosis on the pupil margin and not in the angle
Further testing showed 100 percent occlusion of the right carotid artery. The left carotid artery was stented.
|
|

Methanol Toxic Optic Neuropathy156 views51 year old female lost vision 2 years ago in Indonesia presumably from bad Vodka. She was treated with 1 gram per day steroids. Her vision remains NLP in both eyes. She also suffers from peripheral neuropathy and parkinson's like symptoms.
|
|

BRVO with late onset venous macroaneurysm156 viewsThe vision improved on presentation from 20/160 - 20/32 with Avastin, Then a few years later, he developed a venous Macroaneurysm which was lasered . Avastin shots were then stopped.
|
|

RPE tear following single treatment of vabysmo in the left eye156 views80 year old patient with HemiCRVO and wet AMD in the left eye. The right eye has recent vision loss from 20/40 - 20/100. She has a high PED and wet AMD. She was given one treatment of half-dose vabysmo and presented next visit with a PED tear and vision of 4/200.
|
|

Syphilitic optic neuritis156 viewsTwo weeks ago she woke up with blurred vision in the left eye. She usually gets up at 5 AM. Then she noticed a gray spot in the left eye that did not go away. This is new for her. The gray spot is not getting any better or worse in the left eye. (4/4/23)
Systemic Meds: Lisinopril 40 mg. metformin hydrochloride 1000 MG. nifedipine 30mg
VA OD: sc20/80 PH20/50 NscJ10
VA OS: sc2'/200 Nsc20/400
IOP: TP: OD:15 OS:16
No AC or vitreous cells - later images was with second eye involved with uveitis. Patient received IV PCN and was lost to follow-up
|
|

Syphilitic optic neuritis156 viewsTwo weeks ago she woke up with blurred vision in the left eye. She usually gets up at 5 AM. Then she noticed a gray spot in the left eye that did not go away. This is new for her. The gray spot is not getting any better or worse in the left eye. (4/4/23)
Systemic Meds: Lisinopril 40 mg. metformin hydrochloride 1000 MG. nifedipine 30mg
VA OD: sc20/80 PH20/50 NscJ10
VA OS: sc2'/200 Nsc20/400
IOP: TP: OD:15 OS:16
No AC or vitreous cells - later images was with second eye involved with uveitis. Patient received IV PCN and was lost to follow-up
|
|

Twig (Macular) Branch Retinal Vein Occlusion with no symptoms156 views73 year old female with 20/25 vision and no symptoms
|
|

Radiation Retinopathy Both Eyes - 2023 - Two years after radiation for ocular lymphoma (13)156 views
|
|

Radiation Retinopathy Both Eyes - 2023 - Two years after radiation for ocular lymphoma (15)156 views
|
|

Radiation Retinopathy Both Eyes - 2023 - Two years after radiation for ocular lymphoma (24)156 views
|
|

FEVR and Loeys-Deitz Syndrome - TGFBR gene defect156 views15 year old boy with Loeys-Deitz Syndrome. And TGFBR gene positivity. At age 11 he had aortic root surgery. VA 20/25 OU. Anterior segment normal. Retina shows findings consistent with mild familial exudative vitreoretinopathy
|
|

155 views
|
|

Choroidal Hemangioma Requiring PDT repeatedly155 views64 year old man. Diagnosed with hemangioma in 2015. PDT in 2016. Images are from 2020 when fluid started to reaccumulate. Needed PDT repeated two more times.
PDT treatments: [1] 2/19/2015 -Â Pavan (IOPÂ problem after PDT)Â AND [2] 11/2/21 PDT (7 mm temporal to fovea) - SMCÂ AND [3] 7/22/22 PDT 7.5 mm Temporal to the fovea
|
|

Pattern dystrophy with progressive foveal atrophy left eye155 views72 year old man. Vision in the left eye is 20/80. It declined to 5/200 over about 3 years.
|
|

Macular Serpiginous Chorioretinopathy155 views75 year old vision with central placoid lesions. She tested negative for TB and Syphilis. The final visual acuity in both eyes was 1/200.
|
|

Macular pucker in the left eye155 viewsVision was 20/125 pre-op and 20/25 post-op.
|
|

Macular pucker in the left eye155 viewsVision was 20/125 pre-op and 20/25 post-op.
|
|

Stargardt Disease - Very Mild - 24 year old155 viewsThis patient has 3 different ABCA4 mutations. His mother and sister have stargardts and his father has RP. His sisters images are also on Retinagallery.com
|
|

Methanol Toxic Optic Neuropathy155 views51 year old female lost vision 2 years ago in Indonesia presumably from bad Vodka. She was treated with 1 gram per day steroids. Her vision remains NLP in both eyes. She also suffers from peripheral neuropathy and parkinson's like symptoms.
|
|

RPE tear following single treatment of vabysmo in the left eye155 views80 year old patient with HemiCRVO and wet AMD in the left eye. The right eye has recent vision loss from 20/40 - 20/100. She has a high PED and wet AMD. She was given one treatment of half-dose vabysmo and presented next visit with a PED tear and vision of 4/200.
|
|

Macular ischemia left eye in type I diabetic (enlarged foveal avascular zone)155 views29 year old female with type I diabetes since age 5. Left eye has enlarged FAZ with vision of 20/20 OD and 20/60 OS. Both eyes have CSME. The left eye did have focal laser
|
|

Macular ischemia left eye in type I diabetic (enlarged foveal avascular zone)155 views29 year old female with type I diabetes since age 5. Left eye has enlarged FAZ with vision of 20/20 OD and 20/60 OS. Both eyes have CSME. The left eye did have focal laser
|
|

Disc drusen 8 year old boy - fluorescein shows no leakage155 views8 year old boy with headache and nausea. He had a negative MRI. Images show hyper FAF from drusen and no leakage on FA. No spinal tap was done. VA was 20/40 both eyes.
|
|

Central Serous Chorioretinopathy - Expanding hot spot - photodynamic laser155 views35 year old man with acute central serous chorioretinopathy. The fluid got better then worse and the patient was treated with full strength juxtafoveal PDT and then got better.
|
|

Large chronic choroidal nevus155 viewsAutofluorescence image shows guttering at the bottom of the lesion suggesting chronicity. This was documented 23 years prior to these photos
|
|

central retinal vein occlusion - a lot of hemorrhage - on coumadin155 views84 year old man with severe vision loss left eye for 2 weeks. VA 5/200 OS - Patient on Warfarin for valve replacement.
|
|

central retinal vein occlusion - a lot of hemorrhage - on coumadin155 views84 year old man with severe vision loss left eye for 2 weeks. VA 5/200 OS - Patient on Warfarin for valve replacement.
|
|

Pseudophakic cystoid macular edema (CME)155 views66 year old female 4 months following cataract surgery. Never had very good vision after surgery. On PF QID for one month. VA 20/50 in both eyes.
|
|

Stargardt Disease - Very Mild - 24 year old154 viewsThis patient has 3 different ABCA4 mutations. His mother and sister have stargardts and his father has RP. His sisters images are also on Retinagallery.com
|
|

Stargardt Disease - Very Mild - 24 year old154 viewsThis patient has 3 different ABCA4 mutations. His mother and sister have stargardts and his father has RP. His sisters images are also on Retinagallery.com
|
|

25 year old with Stargard and 2 ABCA4 mutations.154 viewsShe has worn glasses since she was a kid. Since she became an adult her vision started to deteriorate more rapidly. This seems to have been happening since she entered the accounting department for the last two years. Her vision is worse in the light especially when she is driving. She can see green lights in the night but not in the day. She sees better on a dark background than on a light background. Her mom is genetically visually impaired with Stargardts. Her father has RP. The mother was genetically tested in Boston about 23 years ago. That was when the gene was first being isolated. (The mother has seven brothers and sisters and four have stargardts and they are legally blind. Also one cousin has it.)
VA OD: Dcc20/160-1 PH20/80 Ncc20/200-2
VA OS: Dcc20/160-2 PH20/80-1 Ncc20/200-1
IOP: TP: OD:20 OS:21
|
|

25 year old with Stargard and 2 ABCA4 mutations.154 viewsShe has worn glasses since she was a kid. Since she became an adult her vision started to deteriorate more rapidly. This seems to have been happening since she entered the accounting department for the last two years. Her vision is worse in the light especially when she is driving. She can see green lights in the night but not in the day. She sees better on a dark background than on a light background. Her mom is genetically visually impaired with Stargardts. Her father has RP. The mother was genetically tested in Boston about 23 years ago. That was when the gene was first being isolated. (The mother has seven brothers and sisters and four have stargardts and they are legally blind. Also one cousin has it.)
VA OD: Dcc20/160-1 PH20/80 Ncc20/200-2
VA OS: Dcc20/160-2 PH20/80-1 Ncc20/200-1
IOP: TP: OD:20 OS:21
|
|

25 year old with Stargard and 2 ABCA4 mutations.154 viewsShe has worn glasses since she was a kid. Since she became an adult her vision started to deteriorate more rapidly. This seems to have been happening since she entered the accounting department for the last two years. Her vision is worse in the light especially when she is driving. She can see green lights in the night but not in the day. She sees better on a dark background than on a light background. Her mom is genetically visually impaired with Stargardts. Her father has RP. The mother was genetically tested in Boston about 23 years ago. That was when the gene was first being isolated. (The mother has seven brothers and sisters and four have stargardts and they are legally blind. Also one cousin has it.)
VA OD: Dcc20/160-1 PH20/80 Ncc20/200-2
VA OS: Dcc20/160-2 PH20/80-1 Ncc20/200-1
IOP: TP: OD:20 OS:21
|
|

25 year old with Stargard and 2 ABCA4 mutations.154 viewsShe has worn glasses since she was a kid. Since she became an adult her vision started to deteriorate more rapidly. This seems to have been happening since she entered the accounting department for the last two years. Her vision is worse in the light especially when she is driving. She can see green lights in the night but not in the day. She sees better on a dark background than on a light background. Her mom is genetically visually impaired with Stargardts. Her father has RP. The mother was genetically tested in Boston about 23 years ago. That was when the gene was first being isolated. (The mother has seven brothers and sisters and four have stargardts and they are legally blind. Also one cousin has it.)
VA OD: Dcc20/160-1 PH20/80 Ncc20/200-2
VA OS: Dcc20/160-2 PH20/80-1 Ncc20/200-1
IOP: TP: OD:20 OS:21
|
|

BRVO with late onset venous macroaneurysm154 viewsThe vision improved on presentation from 20/160 - 20/32 with Avastin, Then a few years later, he developed a venous Macroaneurysm which was lasered . Avastin shots were then stopped.
|
|

RPE tear following single treatment of vabysmo in the left eye154 views80 year old patient with HemiCRVO and wet AMD in the left eye. The right eye has recent vision loss from 20/40 - 20/100. She has a high PED and wet AMD. She was given one treatment of half-dose vabysmo and presented next visit with a PED tear and vision of 4/200.
|
|

Macular ischemia left eye in type I diabetic (enlarged foveal avascular zone)154 views29 year old female with type I diabetes since age 5. Left eye has enlarged FAZ with vision of 20/20 OD and 20/60 OS. Both eyes have CSME. The left eye did have focal laser
|
|

Disc drusen 8 year old boy - fluorescein shows no leakage154 views8 year old boy with headache and nausea. He had a negative MRI. Images show hyper FAF from drusen and no leakage on FA. No spinal tap was done. VA was 20/40 both eyes.
|
|

Central Serous Chorioretinopathy - Expanding hot spot - photodynamic laser154 views35 year old man with acute central serous chorioretinopathy. The fluid got better then worse and the patient was treated with full strength juxtafoveal PDT and then got better.
|
|

Central Serous Chorioretinopathy - Expanding hot spot - photodynamic laser154 views35 year old man with acute central serous chorioretinopathy. The fluid got better then worse and the patient was treated with full strength juxtafoveal PDT and then got better.
|
|

Central Serous Chorioretinopathy - Expanding hot spot - photodynamic laser154 views35 year old man with acute central serous chorioretinopathy. The fluid got better then worse and the patient was treated with full strength juxtafoveal PDT and then got better.
|
|

Central Serous Chorioretinopathy - Expanding hot spot - photodynamic laser154 views35 year old man with acute central serous chorioretinopathy. The fluid got better then worse and the patient was treated with full strength juxtafoveal PDT and then got better.
|
|

Radiation Retinopathy Both Eyes - 2023 - Two years after radiation for ocular lymphoma (10)154 views
|
|

Dome Shaped Macula Left Eye154 views73 year old female Diagnosed with POHS in the past and treated with laser in the right eye in 1994 with vision loss. She moved from Tampa to Largo in 2017 and started seeing Dr. Cohen. She had her last injection in the left eye 2015 prior to moving to Largo. She has been treated intermittently in the left eye and has been resistant to Anti-VEGF injections. Her vision is good in the left eye. Images are from April 2023 one month following a Vabysmo injection in the left eye.
PMHx- thyroid disease
Meds: Synthroid
VA 20/200 OD, 20/25 OS
|
|

Subhyaloid Hemorrhage, Right Eye153 viewsFundus photograph of 34-year-old woman who presented with sudden onset of flashes and a large black floater obscuring vision in the right eye. Recent history of severe coughing and emisis.
|
|

Macular pucker in the left eye153 viewsVision was 20/125 pre-op and 20/25 post-op.
|
|

Stargardt Disease - Very Mild - 24 year old153 viewsThis patient has 3 different ABCA4 mutations. His mother and sister have stargardts and his father has RP. His sisters images are also on Retinagallery.com
|
|

Methanol Toxic Optic Neuropathy153 views51 year old female lost vision 2 years ago in Indonesia presumably from bad Vodka. She was treated with 1 gram per day steroids. Her vision remains NLP in both eyes. She also suffers from peripheral neuropathy and parkinson's like symptoms.
|
|

BRVO with late onset venous macroaneurysm153 viewsThe vision improved on presentation from 20/160 - 20/32 with Avastin, Then a few years later, he developed a venous Macroaneurysm which was lasered . Avastin shots were then stopped.
|
|

Macular ischemia left eye in type I diabetic (enlarged foveal avascular zone)153 views29 year old female with type I diabetes since age 5. Left eye has enlarged FAZ with vision of 20/20 OD and 20/60 OS. Both eyes have CSME. The left eye did have focal laser
|
|

Central Serous Chorioretinopathy - Expanding hot spot - photodynamic laser153 views35 year old man with acute central serous chorioretinopathy. The fluid got better then worse and the patient was treated with full strength juxtafoveal PDT and then got better.
|
|

Central Serous Chorioretinopathy - Expanding hot spot - photodynamic laser153 views35 year old man with acute central serous chorioretinopathy. The fluid got better then worse and the patient was treated with full strength juxtafoveal PDT and then got better.
|
|

Syphilitic optic neuritis153 viewsTwo weeks ago she woke up with blurred vision in the left eye. She usually gets up at 5 AM. Then she noticed a gray spot in the left eye that did not go away. This is new for her. The gray spot is not getting any better or worse in the left eye. (4/4/23)
Systemic Meds: Lisinopril 40 mg. metformin hydrochloride 1000 MG. nifedipine 30mg
VA OD: sc20/80 PH20/50 NscJ10
VA OS: sc2'/200 Nsc20/400
IOP: TP: OD:15 OS:16
No AC or vitreous cells - later images was with second eye involved with uveitis. Patient received IV PCN and was lost to follow-up
|
|

Pseudophakic cystoid macular edema (CME)153 views66 year old female 4 months following cataract surgery. Never had very good vision after surgery. On PF QID for one month. VA 20/50 in both eyes.
|
|

Radiation Retinopathy Both Eyes - 2023 - Two years after radiation for ocular lymphoma (18)153 views
|
|

Dome Shaped Macula Left Eye153 views73 year old female Diagnosed with POHS in the past and treated with laser in the right eye in 1994 with vision loss. She moved from Tampa to Largo in 2017 and started seeing Dr. Cohen. She had her last injection in the left eye 2015 prior to moving to Largo. She has been treated intermittently in the left eye and has been resistant to Anti-VEGF injections. Her vision is good in the left eye. Images are from April 2023 one month following a Vabysmo injection in the left eye.
PMHx- thyroid disease
Meds: Synthroid
VA 20/200 OD, 20/25 OS
|
|

152 views
|
|

Hydroxychloroquine (plaquenil) Toxicity - Advanced152 views78 year old female No visual complaints referred for evaluation
Medical Hx: Rheumatoid Arthritis. Atrial Fibrillation. Benign Intracranial Hypertension. Sjogrens Syndrome. Osteoporosis.
Systemic Meds: PLAQUENIL (Stopped 2 months ago). Leflunomide. Lidocaine. Gabapentin. Vitamin D. Multaq. DILTIAZEM.
VA OD: Dcc20/32-2 NccJ2
VA OS: Dcc20/25+1 NccJ1-1
IOP: TP: OD:14 OS:15
Color Ishihara OD 9/11 correct, OS 9.5/11 correct
Weight 100 lbs, Height 4’ 2†tall.
1993 Plaquenil Initially 400 mg /day (9 mg/kg/day x 18 years) then 2011 200 mg daily - (4.6 mg/kg/day x 10 years) STOPPED 3/2021
The patient weighs 100 lbs and is 4’ 2†tall - Images are from 3/2021 and 5/2022
There was no progression 1 year after stopping plaquenil in this patient.
|
|

Stargardt Disease - Very Mild - 24 year old152 viewsThis patient has 3 different ABCA4 mutations. His mother and sister have stargardts and his father has RP. His sisters images are also on Retinagallery.com
|
|

Stargardt Disease - Very Mild - 24 year old152 viewsThis patient has 3 different ABCA4 mutations. His mother and sister have stargardts and his father has RP. His sisters images are also on Retinagallery.com
|
|

Disc drusen 8 year old boy - fluorescein shows no leakage152 views8 year old boy with headache and nausea. He had a negative MRI. Images show hyper FAF from drusen and no leakage on FA. No spinal tap was done. VA was 20/40 both eyes.
|
|

Pseudophakic cystoid macular edema (CME)152 views66 year old female 4 months following cataract surgery. Never had very good vision after surgery. On PF QID for one month. VA 20/50 in both eyes.
|
|

Dome Shaped Macula Left Eye152 views73 year old female Diagnosed with POHS in the past and treated with laser in the right eye in 1994 with vision loss. She moved from Tampa to Largo in 2017 and started seeing Dr. Cohen. She had her last injection in the left eye 2015 prior to moving to Largo. She has been treated intermittently in the left eye and has been resistant to Anti-VEGF injections. Her vision is good in the left eye. Images are from April 2023 one month following a Vabysmo injection in the left eye.
PMHx- thyroid disease
Meds: Synthroid
VA 20/200 OD, 20/25 OS
|
|

151 views
|
|

Ocular Ischemia from 100 percent right carotid occlusion151 views77 year old female the vision in the right eye got much worse. She has recently been getting more severe headaches. Her vision is now blank. She went to her old GP in Wisconsin who said it might be sinus pressure. Her chiropractor did an adjustment and the chiropractor checked the patient eyes and told her to go to the eye doctor. She has been feeling pressure around her eye since the air flight.
Specialty Meds (Initial): systane prn OU. Plavix, Combivent, ASA 325, Vitamin E, Zinc.
PSH – Carotid surgery in 2000 (20 years ago), Stent 11/2022, Mastectomy 2000.
VA OD: DccCF 3ft (eccentric) NccUnable
VA OS: Dcc20/25 NccJ1
IOP: TP: OD:18 OS:16
Psuedophakic OU
Right eye had rubeosis on the pupil margin and not in the angle
Further testing showed 100 percent occlusion of the right carotid artery. The left carotid artery was stented.
|
|

Central Serous Chorioretinopathy - Expanding hot spot - photodynamic laser151 views35 year old man with acute central serous chorioretinopathy. The fluid got better then worse and the patient was treated with full strength juxtafoveal PDT and then got better.
|
|

Central Serous Chorioretinopathy - Expanding hot spot - photodynamic laser151 views35 year old man with acute central serous chorioretinopathy. The fluid got better then worse and the patient was treated with full strength juxtafoveal PDT and then got better.
|
|

Syphilitic optic neuritis151 viewsTwo weeks ago she woke up with blurred vision in the left eye. She usually gets up at 5 AM. Then she noticed a gray spot in the left eye that did not go away. This is new for her. The gray spot is not getting any better or worse in the left eye. (4/4/23)
Systemic Meds: Lisinopril 40 mg. metformin hydrochloride 1000 MG. nifedipine 30mg
VA OD: sc20/80 PH20/50 NscJ10
VA OS: sc2'/200 Nsc20/400
IOP: TP: OD:15 OS:16
No AC or vitreous cells - later images was with second eye involved with uveitis. Patient received IV PCN and was lost to follow-up
|
|

FEVR and Loeys-Deitz Syndrome - TGFBR gene defect151 views15 year old boy with Loeys-Deitz Syndrome. And TGFBR gene positivity. At age 11 he had aortic root surgery. VA 20/25 OU. Anterior segment normal. Retina shows findings consistent with mild familial exudative vitreoretinopathy
|
|

Dome Shaped Macula Left Eye151 views73 year old female Diagnosed with POHS in the past and treated with laser in the right eye in 1994 with vision loss. She moved from Tampa to Largo in 2017 and started seeing Dr. Cohen. She had her last injection in the left eye 2015 prior to moving to Largo. She has been treated intermittently in the left eye and has been resistant to Anti-VEGF injections. Her vision is good in the left eye. Images are from April 2023 one month following a Vabysmo injection in the left eye.
PMHx- thyroid disease
Meds: Synthroid
VA 20/200 OD, 20/25 OS
|
|

Dome Shaped Macula Left Eye151 views73 year old female Diagnosed with POHS in the past and treated with laser in the right eye in 1994 with vision loss. She moved from Tampa to Largo in 2017 and started seeing Dr. Cohen. She had her last injection in the left eye 2015 prior to moving to Largo. She has been treated intermittently in the left eye and has been resistant to Anti-VEGF injections. Her vision is good in the left eye. Images are from April 2023 one month following a Vabysmo injection in the left eye.
PMHx- thyroid disease
Meds: Synthroid
VA 20/200 OD, 20/25 OS
|
|

Pigment epithelial detachment with cholesterol crystals150 viewsOnion sign
|
|
17549 files on 176 page(s) |
 |
 |
 |
 |
 |
159 |  |
 |
 |
 |
|